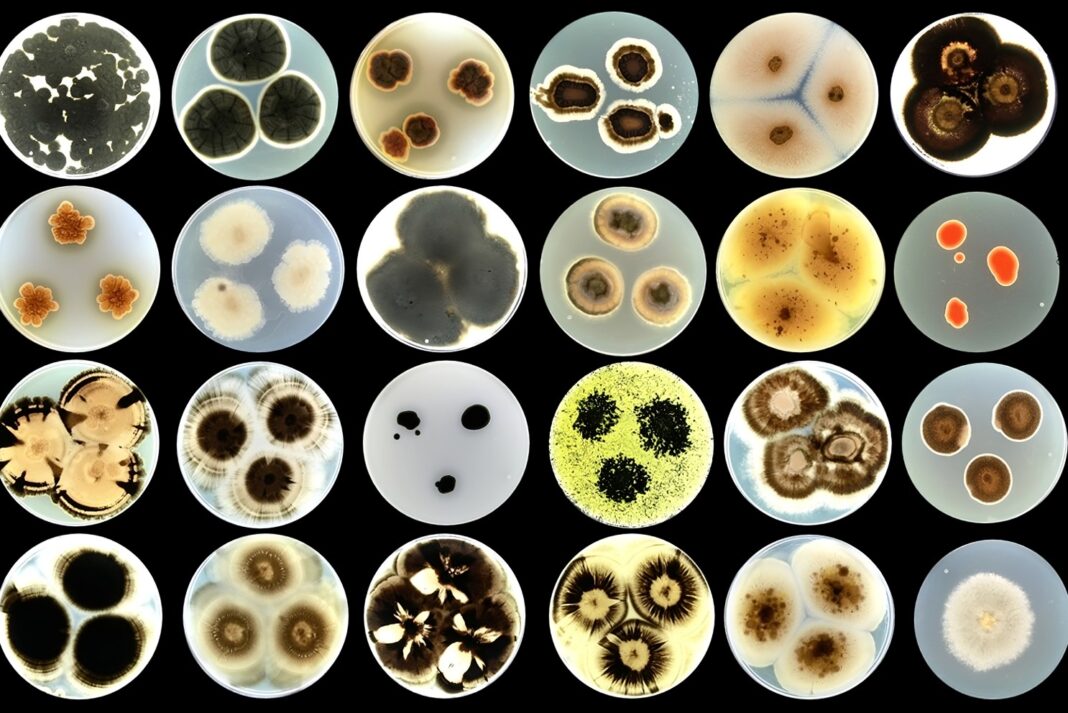

The development of a new coating material inspired by and designed for nature
Many engineering solutions draw inspiration from natural phenomena. Such is the case with the Bioinspired living skin for architecture project, or ARCHI-SKIN. This project stands as one of the most ambitious and innovative research initiatives funded by the European Research Council (ERC) under the Horizon Europe programme. ARCHI-SKIN’s primary objective is the development of a protective coating system. It must be simultaneously bioactive, sustainable, self-healing and eco-friendly, with a design directly inspired by fungal biofilms. It aims to replace current carbon-based building materials that have a negative environmental impact, thus establishing itself as a prime example of innovation for sustainability.
The project will run for 60 months, from 1 September 2022 to 31 August 2027. The coordinator is Dr. Anna Sandak, leader of the Materials Department at InnoRenew CoE in Slovenia. The EU’s contribution to this project is 1.999.000 €.
Background: the reality of the construction sector
Building materials (such as the walls of our homes, their coatings, etc.), must meet a series of technical, aesthetic, and stability requirements. Above all, they must offer lasting resistance to disturbances and weathering. The modern construction industry relies on a wide range of coatings and finishes to protect buildings from these factors, as well as from corrosion and biological degradation. While essential for the longevity of structures, these materials have a problematic environmental profile. A significant portion of these products is derived from petroleum (especially plastics and their derivatives) and other fossil fuels. This intrinsically links them to a carbon-based economy. This link exists not only in terms of production and application but also regarding their difficult disposal.
A consequential problem is the widespread use of biocidal chemicals in coatings, particularly for exteriors. In fact, the growth of microorganisms such as fungi, algae, and bacteria, which thrive under suitable conditions and compromise surfaces, cause most aesthetic and structural damage to architecture.

To prevent their proliferation, paints and textured coatings are enriched with aggressive additives. Although effective in the short term, these compounds slowly disperse into the environment through rain and leaching, contaminating soil and waterways. The core philosophy of ARCHI-SKIN is a complete reversal of this traditional approach. Rather than fighting the biological colonisation of surfaces, the project aims to guide and harness it.
From left to right Dr. Anna Sandak, Principal Investigator, and Dr. Anja Černoša, Postdoctoral Researcher, observing various fungal cultures grown in petri dishes. (1)
Source of inspiration and methodological approach
What is the biological component at the core of the project’s idea? Fungi. Or rather, the component known as a biofilm. A biofilm is essentially a protective structure, formed by aggregates of, at least in this case, fungal microorganisms (though biofilms can also be of bacterial origin) anchored to a self-produced extracellular matrix, primarily composed of water, sugars, and proteins. This matrix, known as EPS, protects the fungal community within, facilitates metabolic exchanges. Most importantly, allows for its proliferation and adhesion to surfaces.
The project’s research phase is divided into several stages. Given the complexity of the materials under study and the ambitious goal, employs various methodologies. ARCHI-SKIN’s research initially focuses on an in-depth study of the design principles governing fungal biofilms. Their formation processes, chemical-physical structure, composition, and adhesive and protective performance are analysed in detail. A crucial step in the project was an exploratory investigation of natural fungal colonisation on various architectural surfaces. This phase helped identify the dominant fungal species best suited for the project. In particular, researchers observed fungi of the Aureobasidium genus. Not only they are among the most common early-stage colonisers, making them promising candidates for the ARCHI-SKIN coating, but they are also highly versatile and adapt to different environments.
What are Engineered Living Materials?
To decode the complexity of the biofilm, a “bottom-up” approach was taken through materiomics research. This latter term describes a holistic approach to studying a material system. A study that aims to understand all its properties and interactions across multiple scales, from the molecule to the macroscopic structure, in order to channel and engineer the observational findings.
A distinctive feature of the ARCHI-SKIN project is its use of multiple cutting-edge, high-throughput methodologies. One of these is in-situ imaging and monitoring, a method for analysing dynamic living systems through time-lapse microscopy and hyperspectral imaging (HI). These techniques allow for real-time observation and monitoring of biofilm growth and its interactions with the substrate directly on the surface. This approach provide an unprecedented amount of data. Another technique used by ARCHI-SKIN is in-silico modelling. It helps to optimise the composition of the ideal nutrient source for the selected fungal strains. This, in turn, accelerates the biofilm engineering process. Computational docking and molecular dynamics simulations model these interactions at the atomic level.



How the Engineered Living Material works
ARCHI-SKIN’s implicit motto is to “work with nature, not against it”. Therefore, it is important to understand the model material at the core of the project: the ELM, or Engineered Living Material. ELMs represent a new class of materials with bio-integrated properties more advanced than even the innovative “smart” materials.
Smart materials are those that react to specific environmental stimuli in a manner consistent with their function. For example, they can change colour as the external temperature changes. The microscopic manipulation of materials to achieve certain effects has existed since the 1950s, thanks to significant developments in chemistry and physics. An example of such materials can be found in bulletproof vests. The fabric, normally soft and elastic, reacts instantly upon the impact of a bullet. An ELM, compared to a smart material, has an even more surprising intrinsic characteristic. It behaves like a biological system, capable of self-replication, self-healing, and self-regulation in response to environmental changes.
Strategic alignment with Europe
ARCHI-SKIN aims not just to be as an academic exercise but to generate a real, measurable impact in the construction sector and to represent frontier research in support of the green transition. Indeed, the project emerges at a time of intense regulatory focus on environmental sustainability and the need for institutions, companies, and private entities to neutralise their carbon footprint. ARCHI-SKIN therefore aligns perfectly with two of Europe’s most important sustainability initiatives: the Chemicals Strategy for Sustainability and the European Green Deal.
The former aims to limit, and subsequently eliminate, the most toxic chemicals in widespread use from the market, replacing them with more eco-sustainable and safer alternatives for human health. The European Green Deal’s objective is deeper and more complex to achieve: it is a flagship strategy aiming to make Europe climate-neutral by 2050. The construction sector is one of the key sectors for this transformation.
ARCHI-SKIN acts directly upon it, not only by introducing its fully bio-based and renewable innovative material but also by promoting the use of sustainable chemical products, in line with the Chemicals Strategy for Sustainability, while seeking to reduce the use of potentially harmful ones.
A paradigm shift for materials
ARCHI-SKIN is pioneering the emerging field of ELM materials. The project is not merely creating a new product; it is helping to define an entirely new category of materials. The ambition, beyond decarbonisation and reducing the environmental impact of construction, is to imbue building materials with a dimension they previously lacked: the properties of a living system. Indeed, the designed coatings are not only bio-inspired and bio-based but will ultimately be composed of living, carefully selected fungal cells, which will give the material its bioremediation and self-healing characteristics. Therein lies the true revolution.
The coating is also designed for a wide range of surfaces, from concrete and stone to wood and plastics, enormously amplifying its potential impact on the construction industry. This opens up the prospect of an architecture that is no longer merely static but dynamic and capable of regeneration. An architecture that can interact and build a relationship with its environment. ARCHI-SKIN’s innovation lies in transforming an inert object into a partially organic system, capable of evolving over time. Does it sound like science fiction? For now, it is a future prospect.